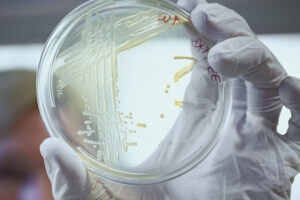
100 Triollionen Keime leben in unserem Darm.

Viele Menschen denken beim Thema Darmgesundheit an unangenehme Symptome wie zum Beispiel Blähungen. Doch ein gesunder Darm ist weit mehr als das reine Verdauungsorgan. Er beeinflusst unser Immunsystem, unseren Stoffwechsel und sogar unsere Stimmung. „Ein gesunder Darm ist die Voraussetzung für einen gesunden Körper. Und Gesundheit wiederum die Basis für Wohlbefinden, Zufriedenheit und Glücksgefühl“, betont Univ.-Prof. Herbert Tilg, Direktor der Univ.-Klinik für Innere Medizin I (Gastroenterologie). Damit rückt die Darmgesundheit zunehmend in den Mittelpunkt der modernen Medizin.
Superorgan Darm
Der Darm ist mit fünf bis sieben Metern Länge und einer Oberfläche von über 30 m² eines der größten Organe des Menschen. Er verarbeitet Nahrung, schützt vor Krankheitserregern und kommuniziert über Nerven- und Botenstoffe mit dem Gehirn. Seine Gesundheit hängt maßgeblich von einem komplexen Ökosystem ab: dem Mikrobiom.
Das Mikrobiom: Ein Superorgan im Superorgan
Im Darm leben mehr als 100 Trillionen Keime, die zusammen rund ein Kilogramm wiegen. Diese „mobile Darmkeimwelt“ nennt man Mikrobiom. Es besteht aus etwa 5.000 Keimfamilien und ist bei jedem Menschen einzigartig. „Ohne dieses ausgeklügelte, mikrobiotische System könnten wir nicht überleben“, erklärt Tilg.
Die Keime bzw. die von ihnen gebildeten Enzyme helfen bei der Verdauung, sie spalten komplexe Kohlenhydrate und machen es möglich, Fasern als Stoffwechselprodukt zu verdauen. Außerdem produzieren die Keime Vitamine und schützen die Darmwand vor schädlichen Eindringlingen.
Wenn das Gleichgewicht verloren geht
Gerät das mikrobiotische System aus dem Gleichgewicht – etwa durch Infektionen, Medikamente, Stress oder ungünstige Ernährung – kann die Barriere an der Darmoberfläche geschwächt werden. Das Immunsystem reagiert empfindlicher, Entzündungen können entstehen, und Beschwerden wie Blähungen, Durchfall oder Bauchschmerzen treten häufiger auf.
Eine gestörte Darmflora wirkt sich aber nicht nur lokal im Darm aus. Sie kann den Hormonhaushalt, den Stoffwechsel und sogar die Psyche beeinflussen. Im Darm werden nämlich Botenstoffe wie Serotonin, Dopamin und Oxytocin gebildet – Hormone, die eng mit Glücksgefühlen verbunden sind. Damit wird verständlich, warum der Darm oft als „zweites Gehirn“ bezeichnet wird.
Wie man Darmgesundheit fördern kann
Ein Drittel aller Erkrankungen unserer westlichen Welt ist laut Herbert Tilg ernährungsbedingt – zu viel Fett, zu viel Zucker, zu viel Salz, zu viel Alkohol. Das ist einerseits erschreckend, aber gleichzeitig liegt in der Ernährung so auch ein Schlüssel zum Erfolg: „Essen und Trinken nehmen für uns Menschen eine zentrale Rolle ein. Als Energielieferant und für die Kalorienzufuhr ist die Nahrungsaufnahme im wahrsten Sinne des Wortes lebensnotwendig. Aber Essen macht uns auch glücklich. Und gesunde Ernährung macht unseren Darm glücklich.“

Besonders wertvoll für den Darm sind ballaststoffreiche Lebensmittel, Kohlblütengewächse wie Karfiol oder Kohlrabi und vielfältige pflanzliche Kost. Alkohol hingegen zerstört die lebensnotwendigen Keime und sollte nur in Maßen konsumiert werden. Eine ausgewogene Ernährung ist für den Ernährungsmediziner entscheidend, der damit auch das „GO“ für einen Burger oder ein paar Stücke Schokolade gibt: „Es ist vollkommen in Ordnung, wenn man ab und zu auch etwas isst, was nicht besonders gesund ist, aber einem schmeckt.“ Bewegung, Schlaf und Stressreduktion unterstützen ebenfalls ein stabiles Mikrobiom.
Vorsorge: Warum die Darmspiegelung so wichtig ist
Auch das Thema Vorsorge spielt eine wichtige Rolle. Vermeintlich unangenehme Untersuchungen werden gerne aufgeschoben, vor allem, solange man keine besonderen Beschwerden hat. Doch die frühzeitige Vorsorge durch eine Darmspiegelung kann Leben retten!

Die Darmspiegelung (Koloskopie) ist eine bewährte Methode, um Darmkrebs-Vorstufen frühzeitig zu erkennen und zu entfernen. Jede Person ab 45 Jahren sollte erstmalig eine Darmspiegelung durchführen lassen.
Diese Untersuchung des Dickdarms wird unter Sedierung – also in einem kontrollierten, medizinischen Dämmerschlaf – mit einem flexiblen, schlauchförmigen Instrument (Endoskop) durchgeführt. An dessen Spitze befinden sich eine Kamera und eine Lichtquelle. So kann die Ärztin oder der Arzt die Darmschleimhaut genau beurteilen. Während der Untersuchung können Polypen entdeckt und oft direkt entfernt werden – ein entscheidender Schritt, um die Entstehung von Darmkrebs zu verhindern.
Veranstaltungstipp: Darmgesundheitstage im DEZ
Darmgesundheitstage – für Ihr gutes Bauchgefühl
- Wann: 12. und 13. März 2026
- Wo: Einkaufszentrum DEZ, Hauptplatz
Besucher:innen können ein begehbares Darmmodell erkunden und das Organ „hautnah“ erleben. Expert:innen der Chirurgie Hall, der Österreichischen Krebshilfe Tirol und der ÖMCCV stehen an Infoständen für persönliche Fragen zur Verfügung – zu Vorsorge, Untersuchungsmethoden, Prävention und Früherkennung.


